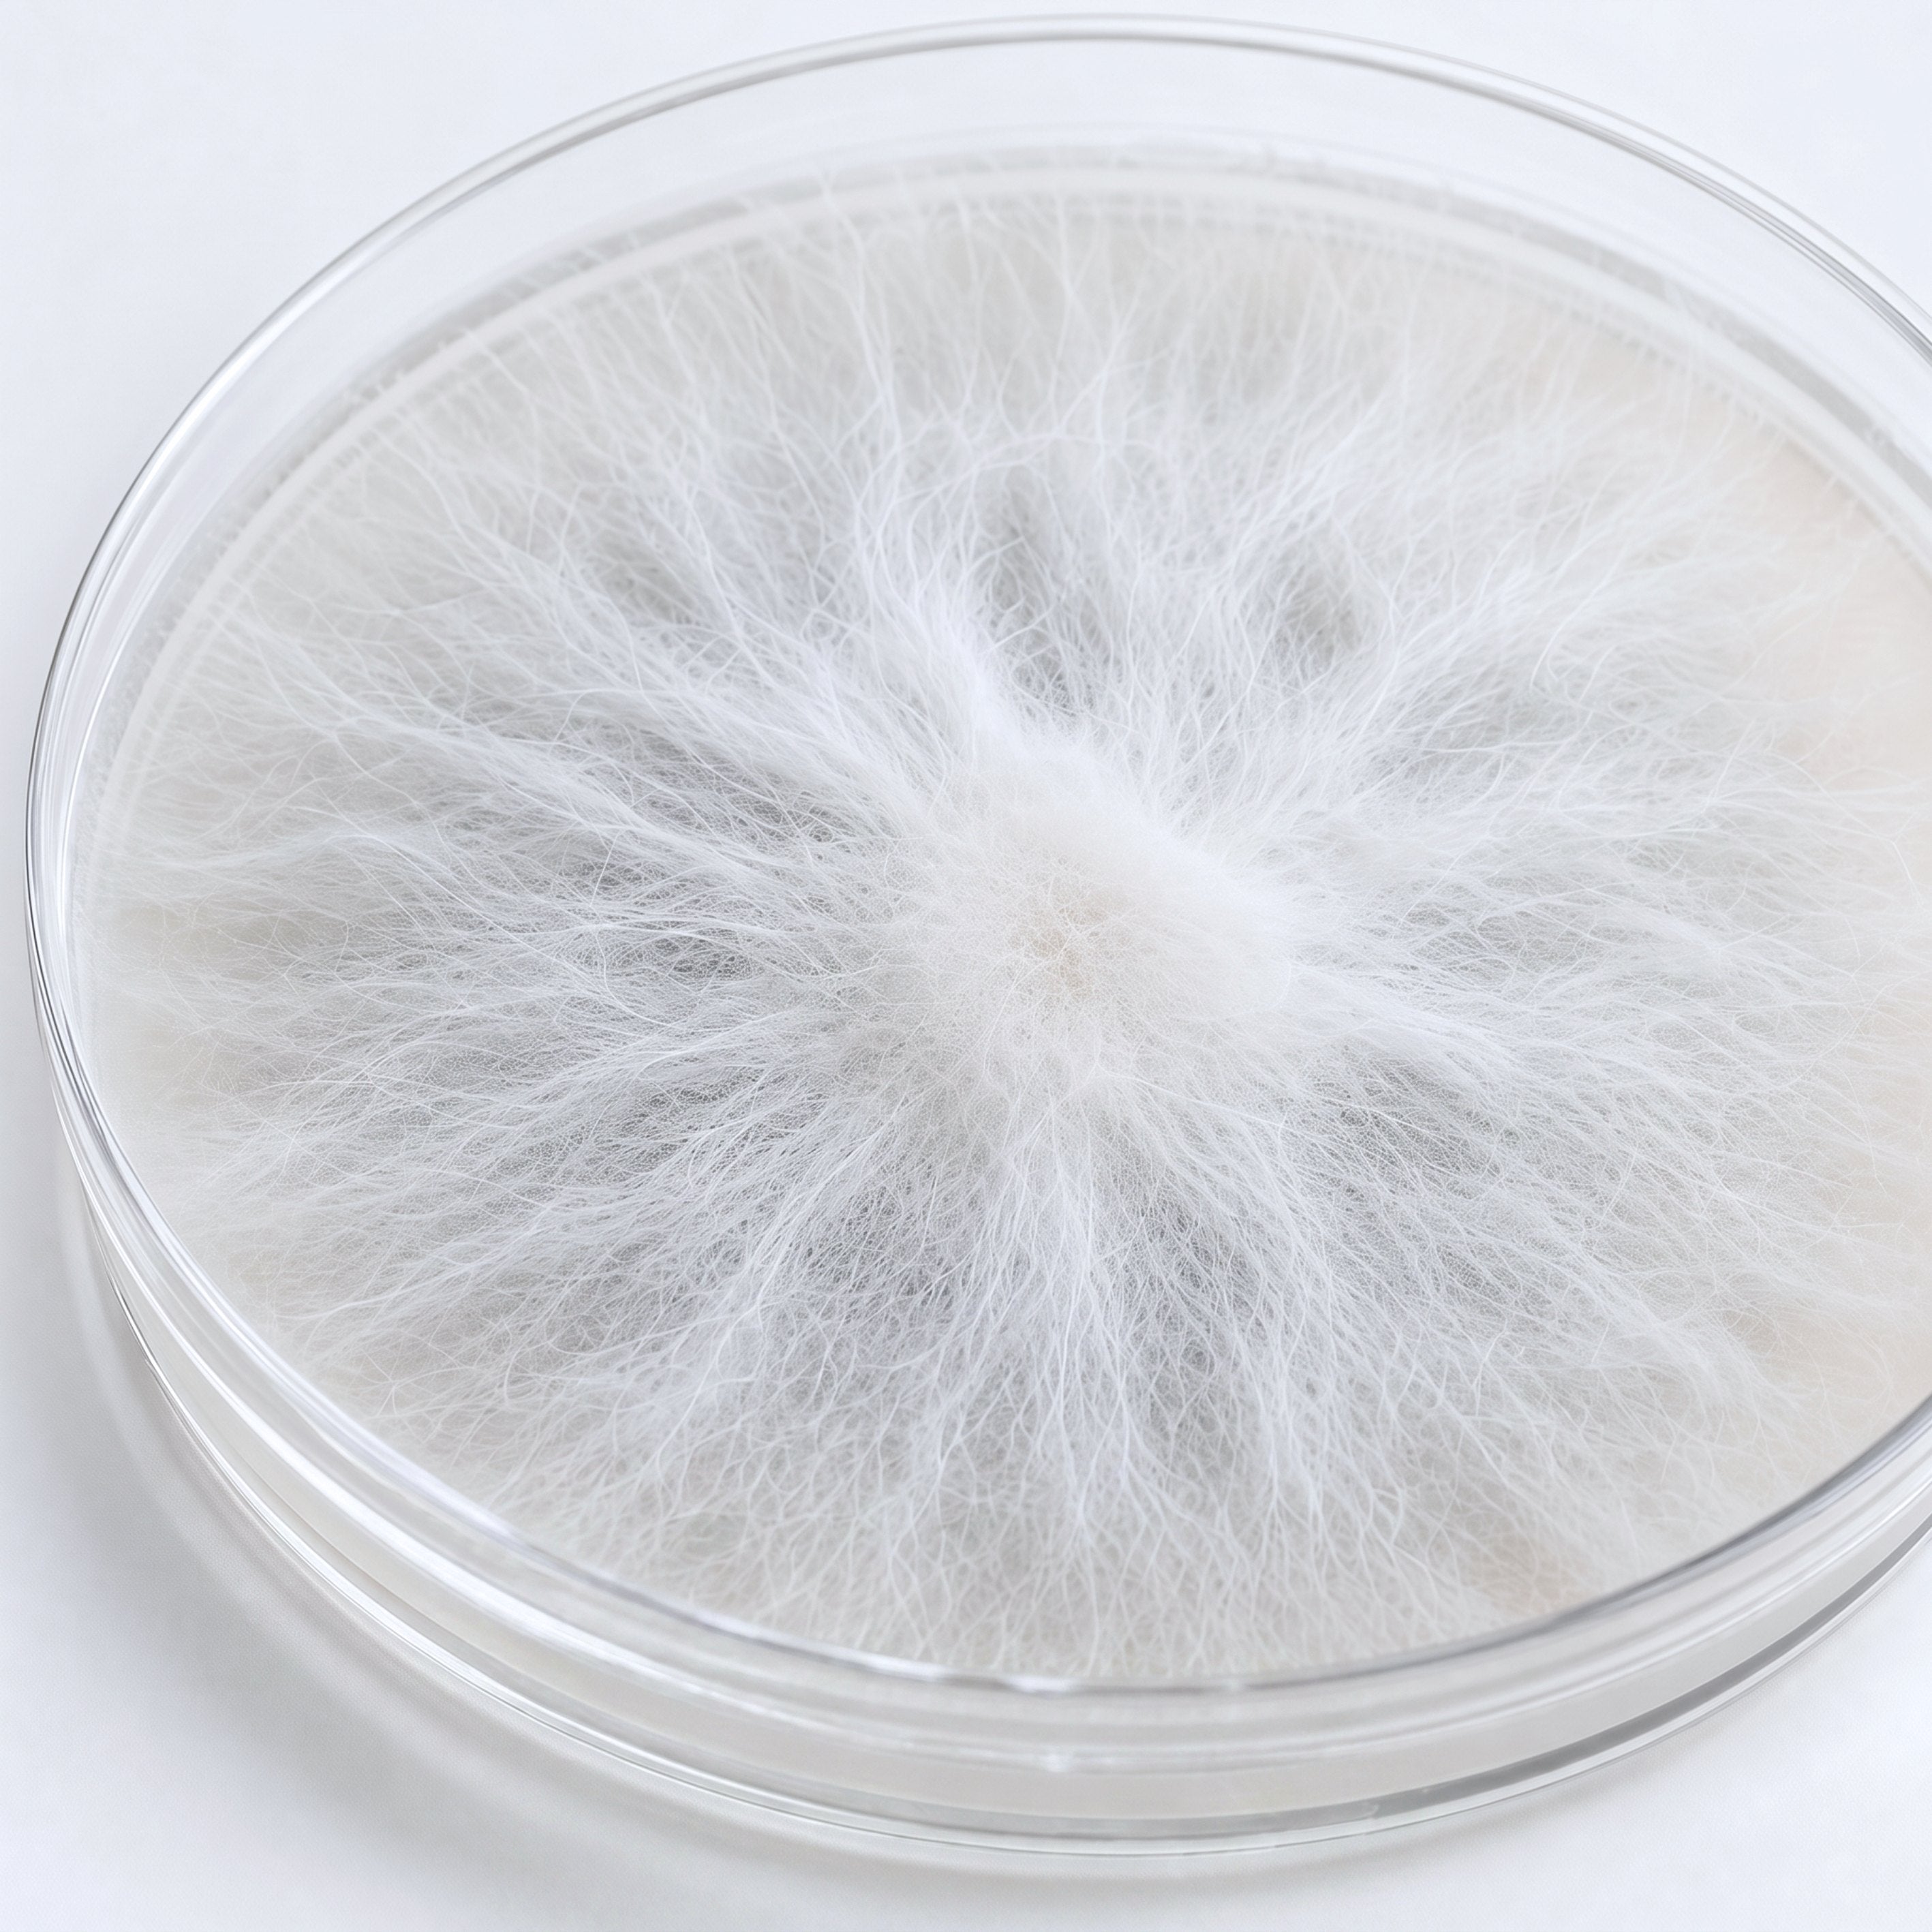

Lion's Mane 01™ - Fruiting Body & Pure Mycelium
Back In Stock! Limited Units Available!
The first Lion’s Mane supplement to combine fruiting body and liquid culture mycelium, delivering maximum cognitive and neurological benefits. Unlike mass-market products grown on grain, our Pure Mycelium™ is cultivated in liquid, yielding significantly higher levels of Erinacine A—the compound responsible for stimulating nerve growth.
How to use
Suggested Use: 2 capsules daily with a meal or as directed by a healthcare professional.
Caution: Take only as directed. Do not exceed the suggested dosage. Pregnant or nursing mothers, children under 18, or individuals with a known medical condition should consult a physician before using this or any dietary supplement. This product may settle during shipping. Natural colors will darken over time. This does not alter the potency of the product. This product is manufactured and packaged in a facility that may also process milk, soy, wheat, egg, peanuts, tree nuts, fish, and crustacean shellfish.
Ingredients
Ingredients:
- Lion's Mane Pure Mycelium 4:1 Extract
- Lion's Mane Fruiting Body 4:1 Extract
- Bioperine (black pepper) Extract
Benefits
- Boosts Mental Clarity – Supports clear thinking and sharp focus throughout the day.
- Enhances Memory – Promotes recall and cognitive function for long-term brain health.
- Elevates Mood – Helps regulate neurotransmitters to support a balanced and positive mindset.
- Supports Nerve Growth – Stimulates Nerve Growth Factor (NGF) to encourage new brain cell development.
- Fast-Acting Formula – Designed for noticeable results, helping you feel the difference quickly.
❤︎
+20,000 people love our product!

No Fillers or Grain

Pure Mycelium

Clinically Studied

GMP Certified

Third-Party Tested

Benefits You Can Actually Feel
✔ Enhanced Focus and Clarity
✔ Neuroprotection & Anti-aging
✔ Mood and Mental Wellbeing
✔ Gut-Brain Axis Support
If you have any questions, you are always welcome to contact us. We'll get back to you as soon as possible, within 24 hours on weekdays.
Shipping Information
Use this text to answer questions in as much detail as possible for your customers.
Customer Support
Use this text to answer questions in as much detail as possible for your customers.
FAQ’s
Use this text to answer questions in as much detail as possible for your customers.
Contact Us
Use this text to answer questions in as much detail as possible for your customers.

Lion's Mane 01™ Protects Your Brain From Aging by Growing New Neurons
Lion’s Mane isn’t just for boosting brainpower—it’s your ally against cognitive aging. By promoting Nerve Growth Factor (NGF), it helps nurture brain cell growth and protect memory, keeping your mind sharp as the years pass.
Loved by our customers!
The First and Only with Pure Mycelium™
The only Lion's Mane supplement that offers both the fruiting body and Pure Mycelium™. Extracted for potency to give you the mental clarity you need to be at your optimal level.

More Erinacines For More Nerve Growth
We are able to provide up to 15 times more Erinacine due to our Pure Mycelium being grown in liquid, whereas our competitors grow their mycelium on grain. The more Erinacine present, the more Nerve Growth Factor gets stimulated, leading to increased focus, mental clarity, and brain longevity.

Premium Quality Your Brain Needs
Lion's Mane 01 is the most advanced Lion’s Mane on the market—dual-sourced for unmatched potency and purity. Don’t settle for watered-down blends when your brain deserves the best
"The brain fog I'd been carrying for two years finally lifted! I didn't realize how dulled I felt until it was gone. I've tried other mushroom supplements — nothing worked like this one."
— DANIELLE M. Verified Customer

The Results Speak for Themselves
90% rated mental clarity
86% rated better mood
80% rated sustained energy
94% rated Increased focus

✓ Love it or your money back!
We're proud to stand behind every sale with a 100% customer satisfaction Guarantee! If you're not completely satisfied with your purchase, reach out for a full refund. Even if the bottle is empty!


























